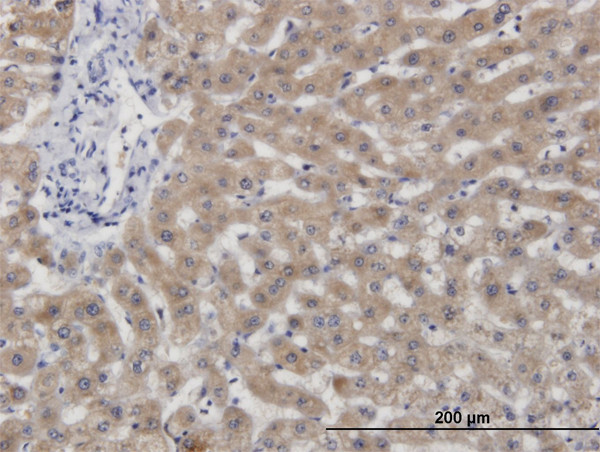
CBS Antibody in Immunohistochemistry (Paraffin) (IHC (P))

Search
Abnova
CBS Monoclonal Antibody (6B8)
{{$productOrderCtrl.translations['antibody.pdp.commerceCard.promotion.promotions']}}
{{$productOrderCtrl.translations['antibody.pdp.commerceCard.promotion.viewpromo']}}
{{$productOrderCtrl.translations['antibody.pdp.commerceCard.promotion.promocode']}}: {{promo.promoCode}} {{promo.promoTitle}} {{promo.promoDescription}}. {{$productOrderCtrl.translations['antibody.pdp.commerceCard.promotion.learnmore']}}
产品信息
H00000875-M05
宿主/亚型
分类
类型
克隆号
抗原
偶联物
形式
浓度
规格
保存条件
运输条件
产品详细信息
Sequence of this protein is as follows: MPSETPQAEV GPTGCPHRSG PHSAKGSLEK GSPEDKEAKE PLWIRPDAPS RCTWQLGRPA SESPHHHTAP AKSPKILPDI LKKIGDTPMV RINKIGKKFG
靶标信息
Only known pyridoxal phosphate-dependent enzyme that contains heme. Important regulator of hydrogen sulfide, especially in the brain, utilizing cysteine instead of serine to catalyze the formation of hydrogen sulfide. Hydrogen sulfide is a gastratransmitter with signaling and cytoprotective effects such as acting as a neuromodulator in the brain to protect neurons against hypoxic injury.
仅用于科研。不用于诊断过程。未经明确授权不得转售。